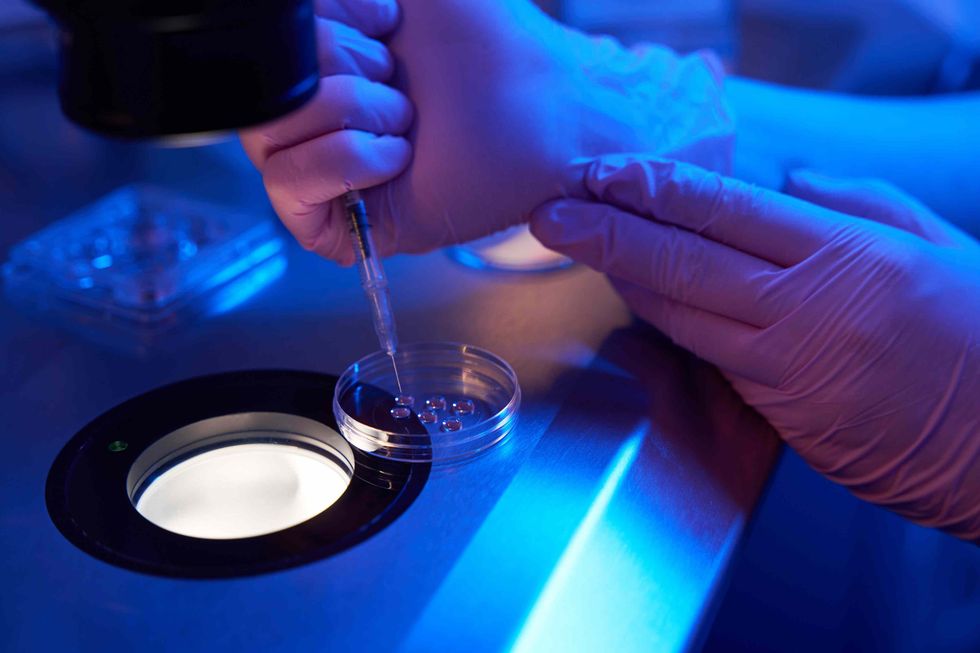

A lindin më shumë djem apo vajza pas fertilizimit in vitro (IVF)? Shanset nuk janë 50-50% - ja pse

Shkencëtarët zbulojnë se ritmi i zhvillimit të embrioneve, algoritmet e përzgjedhjes dhe madje edhe inteligjenca artificiale mund të ndikojnë në përbërjen gjinore të foshnjave të lindura përmes IVF-it
Kur çiftet planifikojnë të kenë fëmijë, shumica besojnë se shanset për vajzë ose djalë janë të barabarta - 50:50. Megjithatë, në rastet kur shtatzënia arrihet përmes fertilizimit in vitro (IVF), mundësia që foshnja të jetë djalë është më e madhe.
Studiuesit kanë zbuluar se embrionet mashkullore zhvillohen pak më shpejt, prandaj ato zgjidhen më shpesh për t’u transferuar në mitër. Kjo është arsyeja pse shanset që një çift që bën IVF të ketë djalë arrijnë deri në 56 nga 100 raste.
“Kur e lidhim zhvillimin më të shpejtë me cilësinë më të mirë, pa vetëdije zgjedhim më shpesh embrionet mashkullore”, shpjegon Dr. Helen O’Neil, specialiste e fertilitetit në Universitetin e Londrës. “Mjetet që përdorim për përzgjedhjen e embrioneve favorizojnë gjininë mashkullore”.
Pse embrionet mashkullore janë “më të shpejta”
Embrionet mashkullore mbartin kromozomet X dhe Y, ndërsa ato femërore dy kromozome X. Ky X shtesë te embrionet femërore sjell një proces shtesë të “çaktivizimit” të një kromozomi X, për të ruajtur ekuilibrin gjenetik, proces që kërkon më shumë energji. Për këtë arsye, embrionet femërore zhvillohen më ngadalë në fazat e para. Si rezultat, në IVF, ku embrionet përzgjidhen sipas ritmit dhe rregullsisë së zhvillimit, embrionet mashkullore kanë një avantazh të vogël, gjë që rrit gjasat të zgjidhen për transferim, shkruan Daily Mail, përcjell Telegrafi.
Edhe inteligjenca artificiale mund të favorizojë embrionet mashkullore
Dr. O’Neil dhe ekipi i saj kanë kryer një studim me 1.300 embrione, gjinia e të cilëve dihej paraprakisht përmes testimit gjenetik. Embrionet janë vlerësuar nga mjekë specialistë dhe dy sisteme të inteligjencës artificiale (AI), të cilat përdorin incizime “time-lapse” të zhvillimit të embrionit.
Rezultatet treguan se:
- Kur mjekët bënin përzgjedhjen, 69% e embrioneve mashkullore u vlerësuan si “të cilësisë së mirë”, krahasuar me 57% të embrioneve femërore.
- Një nga sistemet e AI tregoi gjithashtu prirje të lehtë drejt embrioneve mashkullore, ndërsa tjetri ishte neutral.Edhe pse dallimet janë të vogla, ato mjaftojnë për të krijuar një prirje të lehtë gjinore në statistikat e përzgjedhjes së embrioneve.
A ndikon mosha e nënës në gjininë e fëmijëve?
Një tjetër studim interesant nga Universiteti Harvard analizoi më shumë se 58.000 nëna dhe zbuloi se mosha e nënës në lindjen e fëmijës së parë mund të ndikojë në përbërjen gjinore të pasardhësve.
Gratë që lindën për herë të parë para moshës 23 vjeç kishin 34% gjasa që të kishin fëmijë të së njëjtës gjini. Tek ato që lindën pas moshës 28 vjeç, kjo shifër u rrit në 43%.
Autorët përfunduan se me rritjen e moshës së nënës rritet edhe mundësia që të gjithë fëmijët të jenë të së njëjtës gjini, ndërsa faktorët gjenetikë dhe demografikë kishin ndikim më të vogël.
Si funksionon IVF
Fertilizimi in vitro (IVF) është një procedurë mjekësore në të cilën qeliza vezë fekondohet jashtë trupit, në një laborator, dhe më pas embrioni transferohet në mitër. Kjo metodë përdoret për çifte që kanë vështirësi në ngjizjen natyrale dhe mund të përfshijë qeliza vezë ose spermë të dhuruara. Pas transferimit të embrionit, shtatzënia zhvillohet në mënyrë natyrale, ashtu si te konceptimi natyror.
Suksesi i IVF-it varet nga mosha e gruas dhe shkaqet e infertilitetit, nëse janë të njohura. Sipas statistikave, shanset mesatare për shtatzëni të suksesshme për çdo cikël IVF janë:
- Nën 35 vjeç – 29%
- Nga 35 deri në 37 vjeç – 23%
- Nga 38 deri në 39 vjeç – 15%
- Nga 40 deri në 42 vjeç – 9%Pas moshës 43 vjeç – 3% ose më pak
Ky zbulim thekson se edhe në proceset teknologjike të riprodhimit të asistuar, faktorët biologjikë mbeten vendimtarë dhe se edhe inteligjenca artificiale, sado neutrale të duket, mund të reflektojë prirje të natyrshme gjinore që ndodhin në fazat më të hershme të jetës. /Telegrafi/




















































